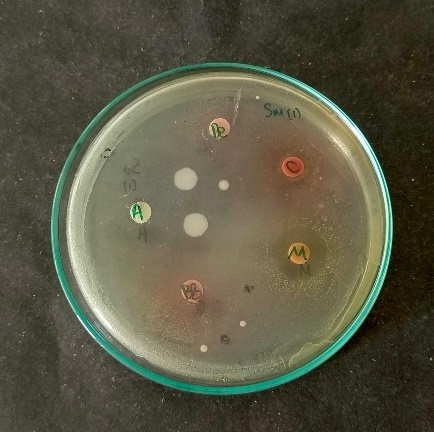

Int J App Pharm, Vol 18, Issue 1, 2026, 568-581Original Article
UNLOCKING THE POTENTIAL OF BETALAIN COMPOUNDS FROM BEETROOT: TARGETING STREPTOCOCCUS MUTANS IN DENTAL CARIES THROUGH MOLECULAR DOCKING, ADMET PROFILING, AND ANTIBACTERIAL ACTIVITY
SOFA FAJRIAH1, NUR FITRIANA1, ILMA FAUZIAH MA’RUF1, RIFALDI1, FADHILA UTARI1, BANTARI WISYNU KUSUMA WARDHANI1,2*, SUSI KUSUMANINGRUM1, YAHDIANA HARAHAP2,3, SRI RATNA LAKSMIASTUTI4, REYNATHA C. A. PANGSIBIDANG2*
1Research Center for Pharmaceutical Ingredients and Traditional Medicine, National Research and Innovation Agency (BRIN), West Java, Indonesia. 2Faculty of Military Pharmacy, Republic Indonesia Defense University, Sentul, West Java. 3Faculty of Pharmacy, Universitas Indonesia, West Java, Indonesia. 4Faculty of Dentistry, Universitas Trisakti, Jakarta, Indonesia
*Corresponding author: Bantari Wisynu Kusuma Wardhani; *Email: bant001@brin.go.id
Received: 29 Apr 2025, Revised and Accepted: 08 Nov 2025
ABSTRACT
Objective: Dental caries, primarily caused by Streptococcus mutans, pose a significant global health challenge, often treated with fluoride and synthetic dyes like erythrosine, despite associated toxicity risks. This study explores betalains, natural pigments from Beta vulgaris (beetroot), as dual-function agents for plaque detection and biofilm inhibition.
Methods: Ten betalains were evaluated through in silico absorption, distribution, metabolism, excretion, and toxicity (ADMET) analysis and molecular docking against glucosyltransferase and antigen I/II (Ag 1/II), key proteins in biofilm formation. Antibacterial activity against S. mutans was performed to determine the inhibition zone and minimum inhibitory concentration (MIC) of beetroot extracts.
Results: Docking validation showed root mean square deviation (RMSD) values below 4 Å, confirming reliability. Isobetanin exhibited the strongest binding affinities (-10.427 and-10.893kcal/mol) and interacted with active residues GLU515 and ASP477, crucial for biofilm formation. High solubility, low toxicity, and limited systemic absorption make betalains ideal for topical applications, such as dental disclosing solutions. In vitro studies have shown that the beetroot ethanol extract from Magelang has higher antibacterial activity than betalains. The beetroot ethanol extract contains not only betalains but also other compounds that synergistically inhibit the growth of S. mutans.
Conclusion: These findings highlight betalains as safer, natural alternatives to synthetic dyes, paving the way for innovative and sustainable dental care formulations with enhanced safety and efficacy. Additionally, further study needs to determine the effectiveness of the extracts in inhibiting dental caries formation.
Keywords: Betalains, Beta vulgaris, Streptococcus mutans, Biofilm inhibition, Glucosyltransferase, Antigen I/II, Dental disclosing solution
© 2026 The Authors. Published by Innovare Academic Sciences Pvt Ltd. This is an open access article under the CC BY license (https://creativecommons.org/licenses/by/4.0/)
DOI: https://dx.doi.org/10.22159/ijap.2026v18i1.54794 Journal homepage: https://innovareacademics.in/journals/index.php/ijap
INTRODUCTION
Streptococcus mutans is a bacterium named as the main cause of dental caries. The microorganism is strongly associated with plaque formation and acid production, which contributes to further enamel deterioration and increases the risk of tooth decay [1]. Dental caries, commonly known as tooth decay, is a pervasive global health issue affecting billions of individuals across all age groups. According to the World Health Organization (WHO), approximately 2 billion people suffer from caries in permanent teeth, while caries in primary teeth impact 514 million children [2]. Current treatments for dental caries primarily rely on fluoride-based methods to inhibit bacterial growth and strengthen enamel. While effective, these approaches have notable limitations. Detection kits for tooth decay, often employing fluoride-based solutions and erythrosine-based plaque-disclosing agents, also face significant challenges. Fluoride, though effective, poses risks of dental fluorosis and potential neurotoxic effects, sparking debates over its safety. Similarly, erythrosine, a synthetic dye used in plaque detection, faces scrutiny due to cytotoxic concerns, leading to restrictions in some countries [1, 3]. These limitations have driven interest in natural alternatives that showed minimum side effects and had broad antimicrobial potential, like betalains and bioactive pigments from beetroots with antioxidant and antimicrobial properties [4, 5]. Betalains are potential dual-action solutions for plaque detection and bacterial inhibition, offering a safer and more sustainable approach to advancing oral healthcare globally [6].
Several recent works on betalains as colored pigments of various plants have pointed out their health-beneficial potential, especially concerning antioxidant and antimicrobial action. Its rich sources can be extracted from Beta vulgaris, commonly known as beetroot [7, 8]. These molecules have attracted great interest for their applications in promising biological and therapeutic contexts, such as fighting oxidative stress and bacterial infections. Despite their huge potential, betalains' effectiveness in inhibiting the activity of S. mutans, which causes dental caries, is unrevealed in many health-related fields [9]. Therefore, further investigation is needed into the potential role of betalains as an alternative supplement therapy targeting S. mutans for better oral health. Alternatively, instead of this, betalain and other constituents from beetroot could be developed as a detection kit for dental caries.
Beetroot comprises mainly betacyanins and betaxanthins. Major betacyanins are betanin, isobetanin, neobetanin, 15-decarboxybetanidin, and 17-decarboxyisobetanidin, whereas vulgaxanthin I, vulgaxanthin IV, valine-betaxanthin, γ-Aminobutric acid-betaxanthin, and isoleucine-betaxanthin are some major betaxanthins [10]. All of them have tremendous potential to be developed into a caries detector, mainly in the form of a disclosing solution. With their colorful appearance and compatibility with living tissues, betalains may become a substitute for natural, nontoxic synthetic dyes in dental plaque detectors. Their inherent bioactive properties, entailing antioxidant and antimicrobial activity, would suggest that the disclosing solution made from betalain may not only exert an inhibitory effect on the formation of dental caries but also have a therapeutic effect by acting on disease-causing oral bacteria, including S. mutans [11, 12]. This dual functionality presents an innovative and scientifically sound approach to enhancing dental diagnostics and preventive care.
Natural pigments, such as anthocyanins, have been considered for therapeutic and diagnostic oral applications; however, their use is discouraged due to their poor stability, as they are highly susceptible to degradation by pH variation, light, oxidation, and elevated temperatures [1]. By comparison, betalains exhibit greater stability across a wider pH range and greater resistance to thermal and photodegradation [2]. For instance, it was recently demonstrated that under storage in the dark, betalain pigments extracted from B. vulgaris exhibited appreciable half-lives, and exposure to light increased degradation substantially [3]. Additionally, comparative overviews of natural pigment stability report that betalains are more robust to a greater range of intrinsic and extrinsic stressors than anthocyanins [3, 4]. Taken together, these findings strengthen the position of betalains as superior candidates to anthocyanins for dual-functional as detection and inhibition agents for dental plaque applications.
Glucosyltransferases are the sucrose-hydrolyzing enzymes produced by S. mutans, which catalyze the formation of glucans elaboration from sucrose that forms the extracellular polysaccharide matrix, playing an essential role in the biofilm formation and bacterial adherence on tooth surfaces. Glucans strengthen the biofilm and promote bacterial colonization and acid production, which, in turn, cause enamel demineralization and dental caries. Hence, glucosyltransferase was a key target for anti-caries therapies aimed at disrupting glucan synthesis [13]. Besides glucosyltransferase, antigen I/II (Ag I/II) is a surface adhesin protein of S. mutans, promoting bacterial attachment to salivary glycoproteins and tooth surfaces, thus playing a crucial role in biofilm formation. Ag I/II facilitates bacterial adherence and interaction with host components [14]. Therefore, Ag I/II has an important role in developing dental plaque and caries, making this antigen another important target for therapeutic intervention.
An efficient but powerful strategy chosen in this research is the in silico approach, which enables the screening and prediction of interaction between natural compounds and bacterial targets, facilitating the precise identification of therapeutic agents. These computational tools assess several compounds without requiring many time-consuming and costly laboratory experiments. Molecular docking enables observation in some instances to make certain predictions on the disposition of bioactive compounds, including betalains, to bind specific bacterial proteins. Its study may predict the binding affinity of active constituents to surface proteins involved in the biofilm formation of S. mutans, which has an important role in bacterial adherence and virulence. In silico methods through molecular docking and absorption, distribution, metabolism, excretion, and toxicity (ADMET) analysis will provide provisional data for the identification of putative anti-biofilm agents and thus provide better efficiency in drug discovery [15–18]. This would be one useful approach toward reducing time and resources in developing new dental diagnostics and preventive care. Researchers also conducted in vitro tests to determine the effectiveness of beetroot ethanol extract and betalain in inhibiting the growth of S. mutans. Therefore, this study aimed to conduct in silico and in vitro tests to explore the potential of B. vulgaris, commonly known as beetroot, to develop a new diagnostic tool for diagnosing and preventing dental caries.
MATERIALS AND METHODS
Plant materials
B. vulgaris L. acquired were collected from the local farmer in three different locations, including West Bandung, Ciwidey, and Magelang. The plants have been identified at Indonesian Herbarium Bogorience, Directorate of Scientific Collection Management, National Research and Innovation Agency Republic (BRIN).
Extraction of samples
The fresh beetroots were cleaned in tap water and peeled, then sliced into thin portions. Each sample then was dried in oven at 40 °C for 48 h with Flap 50%. The dried beetroots then milled into powder. Each powder of beetroots from 3 different locations (100 g) was extracted with 70% ethanol in ratio 10 ml/g at room temperature using the Ultrasonic Assisted Extraction (UAE) for 2 h with three repetitions, respectively. The UAE was conducted using an ultrasonic bath (WT-600-40, Japan) with indirect contact and sonication applied in continuous mode with a power of 600 W and a frequency of 40 kHz. Subsequently, each filtrate underwent evaporation using a rotary evaporator and was then freeze-dried to yield dried extracts, Bandung Barat (49.96%), Ciwidey (43.38%), and Magelang (27.46%).
Determination of the betanin content
In this study, the quantification of betanin content was conducted using Waters’ ACQUITY UPLC System. Calibration curves were established from standard stock solutions of betanin, following the procedure reported by Rotich et al. (2022), with minor modifications [19]. The calibration was performed using betanin solutions at concentrations of 150, 200, 250, 300, 350, and 400 ppm prepared in MeOH/H₂O (1:1). Prior to analysis, samples were filtered through a 0.22 μM nylon syringe filter into Waters amber vials. The UPLC system was equipped with a PDA detector set at 534 nm and an ACQUITY UPLC BEH C18 column (130 Å, 1.7 µm, 2.1 × 50 mm). Analyses were carried out in triplicate under the following conditions: isocratic elution with acetonitrile (50%) and ammonium formate buffer (0.7 mmol) in water (50%) as the mobile phase, a flow rate of 0.4 ml/min, and an injection volume of 4 μL. The column temperature was maintained at 25 °C. Data acquisition and processing were performed using Empower 3 software.
Molecular docking
Data mining
A series of ligands compromised betalains, the major active constituents of B. vulgaris, were selected ten candidates for inhibiting S. mutans including vulgaxanthin-I (Chemspider ID: 32702057), isobetanin (Chemspider ID: 4884836), neobetanin (Chemspider ID: 103883522), valine-betaxanthin (PubChem CID: 157010371), γ-aminobutric acid-betaxanthin (PubChem CID: 136747659), betanin (PubChem CID: 6540685), 17-decarboxyisobetanidin (CAS RN: 104331-28-4), 15-decarboxybetanidin [10, 20], isoleucin-betaxanthin and vulgaxanthin IV [10, 21]. All the structures are depicted in fig. 1. Those ligands were docked with glucosyltransferase and antigen I/II (Ag I/II) from S. mutans, both which play crucial roles in biofilm formation in tooth decay [14].
Drug-likeness and pharmacokinetic analysis
The Drug-likeness and pharmacokinetics properties analysis of betalains were evaluated using the SwissADME server (http://www.swissadme.ch/) based on Lipinski, Ghose, Veber, Egan, and Muegge. Additionally, toxicological assessments, including mutagenicity, carcinogenicity, hepatotoxicity, estrogenicity, androgenicity, acute oral toxicity, skin irritation, and eye irritation, were conducted using the VenomPred server (https://www.mmvsl.it/wp/venompred2/).
Ligands’ preparations
The ligands consist of ten active constituents from B. vulgaris (fig. 1). Ligand structures were constructed using Avogadro [22]. The ligand’s energy was minimized, and the geometry structure was optimized using the UFF force field by using 4 steps per update and steepest descent algorithm. The ligands were converted to. pdbqt format by using PyRx 0.8 [21]. Protonation state of ligand is not adjusted.
Receptor preparations
The crystal structures of glucosyltransferase [Protein Data Bank (PDB) ID: 3AIC] and Ag I/II (PDB ID: 3IPK) from S. mutans involved in biofilm growth were downloaded from RCSB Protein Data Bank (PDB): (https://www.rcsb.org/). Water molecules and ligands present in the protein structure were removed using UCSF Chimera, and the apo structure of the protein was saved in. pdb format. Then the protein’s structure was converted to. pdbqt format by using PyRx 0.8 [21].
Docking protocol validation
Validating the docking methods involved docking the native ligands to the apo structure of the protein using PyRx 0.8 with Vina wizard [23, 24]. Then, the structure of the re-docked native ligand and native ligand on crystal structure were compared. Root mean square deviation (RMSD) was determined by using DockRMSD server https://zhanggroup.org/DockRMSD/ [25]. RMSD value of less than 2Å is excellent and RMSD value of less than 4Å is acceptable, suggesting that the docking protocol used in this study has been carried out successfully [26, 27].
Molecular docking between betalains and surface protein of Streptococcus mutans
Docking was conducted using PyRx 0.8 [23]. Previously optimized ligands and receptors were selected and docked with the Vina wizard feature by using the Run Vina option [24]. The grid box was set as follows to cover the known active site and native ligand on crystal structure. 3AIC (center_x = 190.3478, center_y = 45.6187, center_z = 199.5867, size_x = 30.5268, size_y = 22.8338, size_z = 22.0223). 3IPK (center_x = 6.7079, center_y = 44.8050, center_z = 23.1114, size_x = 34.1401, size_y = 32.2391, size_z = 33.8503).
Analysis and visualization
The best docking results were selected and saved in. pdb format by using UCSF Chimera [28]. Then the protein structure and the docked ligand were combined by using Pymol (https://www.pymol.org/support.html?). Ligand-protein interaction was visualized using PyMol and Discovery Studio sotfware. The active sites of receptor proteins in this study were predicted by PrankWeb (https://prankweb.cz/) with a preference for custom structure used in receptor preparation.
Disk diffusion assay
Inhibitory activity was carried out using the disc method with slight modifications [29]. S. mutans was incubated with brain heart infusion (BHI) agar for 24 h at 37 ˚C. The inoculant was prepared by mixing several bacterial colonies with a sterile ringer solution until a bacterial suspension of 1 x 106 CFU/ml was obtained. The inoculum was taken and streaked on the surface of BHI agar. The samples, betanin, and amoxicillin were dissolved in BHI media. Sterile paper discs with a diameter of 6 mm that had been impregnated with 20 µl** (1000 mg/ml) of the sample were placed on BHI agar. Betanin (1000 mg/ml) and Amoxicillin (0.5 mg/ml) were used as positive controls. The discs were then incubated for 24 h at 37 ˚C. The diameter of the inhibition zone (mm) was measured from the sterile paper disc and the clear zone formed.
Determination of minimum inhibitory concentration
Microdilution test with slight modification was conducted to determine the minimum inhibitory concentration of an extract on bacterial growth [29]. A bacterial suspension of 1 x 108 CFU/ml (0.5 McFarland) was prepared, diluted with physiological NaCl solution to obtain a bacterial suspension of 1 x 106 CFU/ml and then added with a two-fold dilution of the sample into the bacterial suspension in a 96 well plate, incubated for 24 h at 37 ˚C. The MIC value is the lowest concentration that can inhibit bacterial growth.

Fig. 1: The chemical structures of betalains from Beta vulgaris used in this study
RESULTS AND DISCUSSION
Quantification of betanin content
The UPLC chromatograms of betanin standards at concentrations of 150, 200, 250, 300, 350, and 400 ppm are shown in fig. 2 (a–f). The betanin was consistently detected at a retention time (Rt) of 0.44 min, with a maximum absorption wavelength in the range of 534-538 nm. These chromatographic profiles were used to construct the calibration curve (fig. 3), which enabled the quantification of betanin in beetroot extracts.
(a) |
(b) |
(c) |
(d) |
(e) |
(f) |
Fig. 2: Chromatograms for the betanin standard at 150 ppm (a), 200 ppm (b), 250 ppm (c), 300 ppm (d), 350 ppm (e), and 400 ppm (f)

Fig. 3: UPLC calibration curve for betanin standards
The UPLC chromatograms of beetroot extracts are presented in fig. 4 (a-c). Each extract displayed a distinct chromatographic profile, although the characteristic betanin peak was consistently observed at Rt 0.443– 0.447 min. Quantitative analysis using the calibration curve revealed marked differences in betanin content among the samples (table 1). The amount of betanin present in the beetroot was expressed in mg betanin/g dry extract of beetroot. Sample Ciwidey contained the highest concentration of betanin (845.95 mg/g), followed by sample Bandung Barat (748.12±2.72 mg/g). By contrast, sample Magelang exhibited only 15.62±0.24 mg/g, representing the lowest betanin level among the extracts analyzed.
Table 1: Betanin concentration of BB, C, and M beetroot extracts
| No | Samples | Retention time | Peak area | Quantity estimates (mg/g) |
| 1 | Bandung Barat | 0.443 | 27660±102.63 | 748.12±2.72 |
| 2 | Ciwidey | 0.446 | 31351±39.26 | 845.95±1.04 |
| 3 | Magelang | 0.447 | 17±9.09 | 15.62±0.24 |
(a) |
||||
(b) |
||||
(c) |
||||
Fig. 4: UPLC chromatogram dried beetroot extract of Bandung Barat (a), Ciwidey (b), and Magelang (c)
Despite its relatively low betanin concentration, sample Magelang demonstrated additional chromatographic peaks at longer retention times, suggesting a higher abundance of other phytochemical constituents compared to samples Bandung Barat and Ciwidey. Based on the reports by Kusznierewicz et al., 2021, the longer retention times in beetroot extract may be attributed to the betalamic acid and betaxanthin compounds [10]. In addition, the notably higher betanin levels in samples Bandung Barat and Ciwidey suggest that these extracts may possess stronger betacyanin pigment-related bioactivities, whereas sample Magelang may be richer in other phenolic or betaxanthin-pigmented compounds contributing to its overall phytochemical profile [30].
Drug-likeness and pharmacokinetics study
Betalains, pigment compounds isolated from B. vulgaris, are two principal groups: betacyanins and betaxanthins. The main constituents of betacyanins are betanin, isobetanin, neobetanin, 15-decarboxybetanidin, and 17-decarboxy isobetadine, while representative betaxanthins are vulgaxanthin I, leucine betaxanthin/vulgaxanthin IV, valine betaxanthin, γ-aminobutyric acid betaxanthin, and isoleucine betaxanthin [10]. The in silico ADMET study was performed via SwissADME servers to predict the absorption, distribution, metabolism, excretion, and toxicity properties of these compounds [31, 32]. Betanin, isobetanin, and neobetanin deviated from certain drug-likeness criteria, primarily due to higher molecular weights and hydrogen bonding deviations (table 2). Nevertheless, these factors are less critical for topical applications, such as dental disclosing solutions. A higher MW can sometimes be acceptable, particularly if the compound has good solubility and appropriate lipophilicity (logP) to allow for adequate absorption [33]. Interestingly there were many studies reveal that drugs with molecular weight around 500 Da were applied for topical use such as tacrolimus (~800 Da) that has function as topical immunosuppressant [34], cyclosporin derivatives (~1200 Da) that were applied to treat inflammatory skin disease [35], and hyaluronan (500–1200 kDa) used to attenuate inflammatory and neurophatic pain [36]. All betalains demonstrated high solubility, supporting their formulation into aqueous dental solution. Their low skin permeability, indicated by negative log Kp values, enhances their suitability for topical use, while minimal blood-brain barrier permeability reduces potential side effects in central neural systems (table 2). Importantly, none of the betalains interact with CYP enzymes, indicating a low likelihood of drug-drug interactions. Moderate synthetic accessibility scores in the range of 4.05-6.08 suggest reasonable feasibility for production. Similar to these findings, studies have demonstrated the favorable pharmacokinetics and drug-likeness of betalains contribute to their inhibition S. mutans adhesion on in vitro studies [14]. In tuberculosis drug development, the favorable pharmacokinetics and drug-likeness of decoquinate RMB041 offer promising insights, particularly regarding its oral bioavailability, as demonstrated through an in silico approach. The findings presented in this study provide a valuable foundation for designing drugs that not only have the potential to shorten the tuberculosis treatment regimen but also minimize adverse effects, thereby improving patient outcome [37]. Other studies revealed that in silico and in vitro results demonstrate strong concordance in developing natural anthelminthic therapies. In silico results revealed samaragenin A and samaragenin B, active compounds in Syzygium aqueum as a potent inhibitor of ATP-dependent 6-phosphofructokinase, showing high binding affinities and favorable pharmacokinetics profile. It’s aligned with in vitro studies, where S. aqueum extract significantly affected worm paralysis and mortality [38].
Toxicology study
The toxicological analysis of betalains from B. vulgaris showed a range of safety profiles for the ten molecules evaluated, as detailed in table 2. The mutagenicity scores varied from 25% to 61%, with neobetanin having the highest score. Carcinogenicity scores were between 26% and 61%, with betanin and neobetanin also showing elevated values. Hepatotoxicity, an important factor in safety assessment, ranged from 35% to 58%, with betanin and isoleucine-betaxanthin recording the highest levels. Regarding endocrine disruption, both estrogenicity and androgenicity scores were below 37%, suggesting a relatively low risk. Acute oral toxicity ranged from 16% to 39%, while skin and eye irritation scores were moderate, mostly under 25%. Notably, 15-decarboxybetanidin and valine-betaxanthin had lower scores across most toxicity parameters, indicating a safer toxicological profile. The toxicological analysis highlights the diverse safety profiles of betalains, pointing out their potential risks and benefits for topical applications. Betanin and neobetanin showed favorable pharmacokinetics and solubility but also higher mutagenicity and hepatotoxicity scores, indicating the need for further experimental validation before considering therapeutic uses. In contrast, compounds like 15-decarboxybetanidin and valine-betaxanthin exhibited lower toxicity scores across most parameters, making them safer options for dental disclosing solutions or other topical formulations. The generally low estrogenicity and androgenicity scores for all molecules suggest minimal potential for endocrine disruption, which is beneficial for oral health applications. Although hepatotoxicity scores for several betalains are moderately high (e. g., 57% for betanin and 56% for neobetanin), this risk is less significant for topical applications due to limited systemic absorption, as indicated by the low skin permeability (negative log).
The results of the toxicological analysis are presented in table 2. The results provided insights into safety profiles, which showed low overall mutagenicity, carcinogenicity, estrogenicity, and androgenicity scores, thus within relatively safe profile scores. However, the hepatotoxicity scores have ranged between 55 and 59%, indicating a potential risk, though at a moderate level, to which attention should be given in cases of accidental ingestion or upon long exposure. This aspect, however, needs further deliberation in the context of experimental studies regarding safety, especially for a product to be used within the oral cavity. The results indicate the promising potential of beetroot extract, especially its betalain content, for developing a dental plaque-disclosing solution. Major betalains, like betanin and isobetanin, exhibit proper solubility for inclusion in such a solution. Additionally, their vivid coloring properties make them excellent candidates for effectively staining dental plaque. While some compounds may face pharmacokinetic challenges in drug development, this is less concerning for a topical application like a disclosing solution, where absorption and bioavailability are not critical. The antioxidant and antimicrobial properties of betalains could also offer added benefits by helping detect plaque and providing mild antimicrobial activity, potentially reducing bacterial load, including S. mutans, a key player in dental plaque formation. Minimal skin and eye irritation further enhance the safety profile of betalain-based solutions for oral care. The toxicology properties correspond closely with observed in vitro antibacterial efficacy, indicating a strong alignment between computational predictions and biological outcomes [39]. In the same way, decoquinate’s in silico toxicology profile supports its demonstrated in vitro activity, highlighting its potential as an effective oral anti-tuberculosis agent with minimal adverse effects [37].

Fig. 5: Docking validation to compare the geometry of the native ligand (yellow) and docked native ligand (blue). A Glucosyltransferase and B Ag I/II
Table 2: Physicochemical properties, pharmacokinetics and toxicological analysis of betalains from B. vulgaris
| Physicochemical properties | ||||||||||
| Betanin (1) | Isobetanin (2) | Neobetanin (3) | 15-Decarboxybetanidin (4) | 17-Decarboxyisobetanidin (5) | Vulgaxanthin I (6) | Leucin betaxanthin_vulgaxanthin IV (7) | Valine-betaxanthin (8) | γ-Aminobutric acid-betaxanthin (9) | Isoleucin-betaxanthin (10) | |
| Molecular weights (Da) | 550.47 | 546.44 | 548.45 | 344.32 | 344.32 | 339.30 | 324.33 | 310.30 | 296.28 | 324.33 |
| H-bond acceptors | 14 | 14 | 14 | 7 | 7 | 8 | 7 | 7 | 7 | 7 |
| H-bond donors | 8 | 8 | 8 | 4 | 4 | 5 | 4 | 4 | 4 | 4 |
| Fraction Csp3 | 0.42 | 0.25 | 0.33 | 0.24 | 0.24 | 0.36 | 0.47 | 0.43 | 0.38 | 0.47 |
| Rotatable bonds | 8 | 8 | 8 | 4 | 4 | 8 | 7 | 6 | 7 | 7 |
| Molar refractivity | 135.13 | 134.46 | 130.51 | 96.43 | 96.43 | 84.97 | 86.87 | 82.07 | 77.26 | 86.87 |
| TPSA (Å2) | 247.11 | 247.11 | 247.64 | 130.66 | 130.66 | 179.38 | 136.29 | 136.29 | 136.29 | 136.29 |
| Consensus Log-P | -1.54 | -1.42 | -1.48 | 0.76 | 0.54 | -1.31 | 0.32 | 0.06 | -0.43 | 0.33 |
| ESOL Log-S | -2.05 | -1.75 | -2.83 | -2.37 | -2.27 | -0.66 | -2.20 | -1.95 | -1.00 | -2.20 |
| ESOL class | Soluble | Very soluble | soluble | Soluble | Soluble | Very soluble | Soluble | Very soluble | Very soluble | Soluble |
| Lipinski violation | 3 | 3 | 3 | 0 | 0 | 0 | 0 | 0 | 0 | 0 |
| Ghose violation | 3 | 2 | 3 | 0 | 0 | 1 | 0 | 0 | 0 | 0 |
| Veber violation | 1 | 1 | 1 | 0 | 0 | 1 | 0 | 0 | 0 | 0 |
| Egan violation | 1 | 1 | 1 | 0 | 0 | 1 | 1 | 1 | 1 | 1 |
| Muegge violation | 3 | 3 | 3 | 0 | 0 | 1 | 0 | 0 | 0 | 0 |
| Bioavailability score | 0.11 | 0.11 | 0.11 | 0.56 | 0.56 | 0.11 | 0.56 | 0.56 | 0.56 | 0.56 |
| Synthetic accessibility | 6.03 | 6.08 | 5.37 | 4.05 | 4.29 | 4.62 | 4.69 | 4.59 | 4.14 | 4.88 |
| Pharmacokinetics | ||||||||||
| GI Absorption | Low | Low | Low | High | High | Low | High | High | High | High |
| BBB permeant | No | No | No | No | No | No | No | No | N | No |
| Pgp substrate | No | Yes | No | No | No | No | No | No | No | No |
| Cyp 1A2 inhibitor | No | No | No | No | No | No | No | No | No | No |
| Cyp 2C19 inhibitor | No | No | No | No | No | No | No | No | No | No |
| Cyp 2C9 inhibitor | No | No | No | No | No | No | No | No | No | No |
| Cyp 2D6 inhibitor | No | No | No | No | No | No | No | No | No | No |
| Cyp 3A4 inhibitor | No | No | No | No | No | No | No | No | No | No |
| Log-Kp (skin permeation (cm/s) | -10.55 | -10.70 | -9.77 | -7.86 | -7.97 | -9.22 | -7.36 | -7.53 | -8.35 | -7.36 |
| Toxicological Scores (%) | ||||||||||
| Mutagenicity | 33 | 33 | 38 | 26 | 35 | 31 | 30 | 27 | 25 | 31 |
| Carcinogenicity | 42 | 42 | 61 | 41 | 38 | 40 | 38 | 35 | 26 | 38 |
| Hepatotoxicity | 57 | 57 | 56 | 54 | 55 | 59 | 56 | 56 | 55 | 57 |
| Estrogenicity | 28 | 28 | 28 | 35 | 36 | 4 | 3 | 3 | 6 | 3 |
| Androgenicity | 16 | 16 | 17 | 17 | 15 | 8 | 8 | 7 | 7 | 8 |
| Acute Oral toxicity | 33 | 33 | 31 | 33 | 39 | 19 | 16 | 17 | 20 | 18 |
| Skin irritation | 6 | 6 | 7 | 11 | 11 | 18 | 26 | 26 | 24 | 23 |
| Eye irritation | 8 | 8 | 4 | 22 | 13 | 12 | 17 | 17 | 23 | 18 |
Binding interactions with glucosyltransferase and Ag I/II
The docking validation process employed Root mean Square Deviation (RMSD) values to compare re-docked native ligand to the position of native ligand on the crystal structure of glucosyltransferase and Ag I/II proteins. The RMSD values for glucosyltransferase and Ag I/II were 0.449 Å and 3.790 Å, respectively (table 3 and fig. 5), indicating robust docking accuracy. RMSD<2 Å is typically regarded as an outstanding re-docking performance, whereas RMSD<4 Å is regarded as acceptable [26, 27]. Ensuring that the docking protocol can reliably predict ligand binding conformations. Such validation is crucial in molecular docking studies to ensure the credibility of subsequent interaction and binding affinity analyses. The low RMSD values validate the reliability of the docking method and its ability to reproduce native ligand conformations accurately. This accuracy is pivotal when studying the interactions of B. vulgaris (beetroot)-derived compounds with target proteins associated with biofilm formation, particularly S. mutans proteins such as glucosyltransferase and Ag I/II. Comparable studies, like those analyzing quorum-sensing inhibitors for biofilm disruption in Pseudomonas aeruginosa [40], have similarly emphasized the importance of docking validation for identifying promising compounds with anti-biofilm potential. Furthermore, Martins et al. (2021) highlight that precise docking outcomes facilitate identifying key ligand-receptor interactions, a necessary step before molecular dynamics simulations and experimental validations [38, 41]. In this study, validated docking methods provide the foundation for subsequent analysis of beetroot compounds.
Table 3: RMSD value of re-docked native ligand compared to the position of native ligand on the crystal structure to validate the docking method
| No | Compared ligand | RMSD (Å) |
| 1 | Re-docked native ligand of glucosyltransferase | 0.449 |
| 2 | Re-docked native ligand Ag I/II | 3.790 |
Following those results, the molecular docking binding affinity of bioactive compounds betalains from B. vulgaris with glucosyltransferase (fig. 6A) and Ag I/II (fig. 6B), key proteins involved in S. mutans biofilm formation, were shown in table 4. Isobetanin was found to have the highest binding affinity with glucosyltransferase (-10.427 kcal/mol) and Ag I/II (-10.893 kcal/mol), followed closely by betanin and neobetanin with-8.842 and-9.324 kcal/mol for glucosyltransferase, and neobetanin and betanin with-10.116 and-9.878 kcal/mol for Ag I/II. These values depict strong inhibitory potential in contrast to erythrosine (-7.945and-8.273 kcal/mol), erythromycin (-7.634 and-7.471 kcal/mol) and native ligand phenylmethanesulfonic acid (-5.278 kcal/mol for Ag I/II). The reference compound alpha-acarbose exhibited maximum affinity in the glucosyltransferase-active site at an interaction energy of-14.561 kcal/mol, hence validating the accuracy of the docking.
The interaction is observed in tables 5 and 6. It describes specific hydrogen and hydrophobic interactions involving active site residues between the ligands and target proteins, including GLU515, ASP477, and ASP588 in glucosyltransferase and SER697, GLU706, and ARG824 in Ag I/II (fig. 7), that provide strong evidence for its disrupting biofilm formation. Other pure compounds, such as betanin and isobetanin, also showed excellent interactions with these active sites, contributing to their high binding affinities. Isobetanin forming hydrogen bond with glycosyltransferase involving ASP477, SER589, TYR610, ASP909, ASN914, GLN960 and forming hydrophobic interaction involving LEU433, LEU434, ALA478, ASN481, TRP517, LEU544, HIS587, GLU590, ASN862, LEU908, VAL957, this compound also form attractive interaction with active site GLU515 and ASP588. Meanwhile, comparison with less effective betalain such as vulgaxanthin 1 shows that this betalain does not form hydrogen bond with active site ASP477, GLU515 or ASP588 (data not shown). Furthermore, comparison with native ligand alpha acarbose show that isobetanin show similar hydrogen bond with native ligand involving ASP477, ASP909, GLN960 and hydrophobic interaction involving LEU433, LEU434, ALA478, TRP517, HIS587, ASN862, VAL957. This finding support that particular betalain such as isobetanin is potential inhibitor of glycosyltransferase. Similar findings were obtained by Knoll et al. in 2022 with Mycobacterium tuberculosis, where in silico docking highlighted important ligand-receptor interactions further validated by in vitro assays, showing the translational value of such an in silico approach [37]. The dual focus on hydrogen and hydrophobic interactions makes for a strong assertion in making the case of betalains as potent inhibitors of biofilms since effective interaction patterns are crucial for high binding affinities-a concept also reinforced during analysis of natural biofilm disruptors [38, 41].

Fig. 6: The binding site of native ligand (yellow), betanin (dark blue), isobetanin (orange), neobetanin (magenta), erythrosine (cyan), and erythromycin (red). A. glucosyltransferase and B. Ag I/II
Table 4: Molecular docking result of betalains with glycosiltransferase and Ag I/II
| No. | Ligand | Binding affinity (kcal/mol) | |
| Glucosyltransferase | Ag I/II | ||
| 1 | Native ligand/alpha acarbose | -14.561 | |
| 2 | Native ligand/phenylmethanesulfonic acid | -5.278 | |
| 3 | Betanin (1) | -9.324 | -9.878 |
| 4 | Isobetanin (2) | -10.427 | -10.893 |
| 5 | Neobetanin (3) | -8.842 | -10.116 |
| 6 | 15-Decarboxybetanidin (4) | -8.077 | -8.555 |
| 7 | 17-Decarboxyisobetanidin (5) | -7.937 | -8.627 |
| 8 | vulgaxanthin I (6) | -8.031 | -7.687 |
| 9 | Leucin betaxanthin_vulgaxanthin IV (7) | -7.635 | -7.729 |
| 10 | Valine-betaxanthin (8) | -7.716 | -7.405 |
| 11 | γ-Aminobutric acid-betaxanthin (9) | -7.297 | -6.945 |
| 12 | Isoleucin-betaxanthin (10) | -7.615 | -7.271 |
| 13 | Erythrosine | -7.945 | -8.273 |
| 14 | Erythromicin | -7.634 | -7.471 |
The docking results provide evidence for the betalains, particularly isobetanin, betanin and neobetanin, as potentially active inhibitors of S. mutans biofilm formation. Neobetanin, based on its high binding affinity and critical contacts with active site residues, is likely to interfere with the enzymatic functions of glucosyltransferase and with the adhesive properties of Ag I/II (fig. 8). These findings concur with previous studies reporting that natural compounds have a crucial role in targeting pivotal proteins of biofilm development. Furthermore, the strong binding affinities of betalains, particularly neobetanin, isobetanin, and betanin, underscore their potential inhibitor of key S. mutans biofilm-forming properties. Regarding Suwendar et al. (2024), in silico results were corroborated by an in vitro study, which confirmed inhibitory bacterial biofilm forming [38].

Fig. 7: 3-dimensional (left) and 2-dimensional ligand interaction with glucosyltransferase. A. native ligand (yellow), B. Betanin (dark blue), C. Isobetanin (orange), D. Neobetanin (magenta), E. Erythrosine (cyan) and F. Erythromicin (red). Hydrogen interactions (grey) and hydrophobic interactions (limon) are shown in 3-dimentional fig. (left)

Fig. 8: 3-dimensional (left) and 2-dimensional ligand interaction with Ag I/II. A. native ligand (yellow), B. Betanin (dark blue), C. Isobetanin (orange), D. Neobetanin (magenta), E. Erythrosine (cyan) and F. Erythromicin (red). Hydrogen interactions (grey) and hydrophobic interactions (limon) are shown in 3-dimentional fig. (left)
Compared to erythrosine, the synthetic dye generally used in dental plaque-disclosing solutions, betalains exhibited higher binding affinities and more interactions with essential active sites. It supports the idea of replacing synthetic agents with natural alternatives that offer minimal or no toxicity while maintaining or exceeding efficacy. Additionally, interactions of isobetanin, betanin, and neobetanin with critical residues GLU515 and ASP477 in glucosyltransferase align with studies highlighting the role of these amino acids in inhibiting glucosyltransferase enzymatic activity. Furthermore, the findings suggest that betalains may act as dual-function agents; in addition to plaque detection enabled by their bright color, they may interfere with microbial biofilm formation. Future studies using molecular dynamics and in vitro validation will help confirm the stability and efficacy of the interactions of betalains with proteins under physiological conditions, paving the way for developing safer and more effective dental care formulations. Furthermore, isobetanin, betanin, and neobetanin also have higher binding affinities than erythromycin. Erythromycin is effective antibiotic against S. mutans, a type of bacteria that can cause tooth decay [42].
Table 5: Amino acids on glycosyltransferase in-volve in hydrogen and hydrophobic interaction with native ligand, betanin, isobetanin and neobetanin
| No. | Ligand | Amino acid residues | |||
| Hydrogen interaction | Hydrophobic interaction | Salt bridge/Attractive charge/Pi-Cation | Pi-Pi stacked/Alkyl | ||
| 1 | Native ligand | TYR430, ASP477, GLU515, ASP588, PHE907, ASP909, GLN960 | LEU433, LEU434, ARG475, ALA478, VAL479, ASP480, TRP517, ASN537, LEU541, HIS587, SER589, GLN592, ASN862, ASN914, TYR916, VAL957 | ||
| 2 | Betanin (1) | TYR430, ASP480, ASN481, GLU515, GLN592, ASP909, ASN914, GLN960 | ASP424, THR426, GLY428, GLY429, LEU433, LEU434, ALA478, SER518, TYR519, HIS587, SER589, ASN862, PHE907, LEU908, VAL957 | ASP477, ASP588, ASP909, TYR916 | TRP517 |
| 3 | Isobetanin (2) | ASP477, SER589, TYR610, ASP909, ASN914, GLN960 | LEU433, LEU434, ALA478, ASN481, TRP517, LEU544, HIS587, GLU590, ASN862, LEU908, VAL957 | GLU515, ASP588, ASP593, ASP909 | PHE907, TYR916 |
| 4 | Neobetanin (3) | ASP909, GLN960 | LEU382, ASP424, THR426, GLY428, GLY429, LEU434, ASP477, ALA478, ASP480, ASN481, GLU515, SER518, TYR519, HIS587, GLN592, TYR610, ASN862, LEU908, ASN914, VAL957 | ASP588 | LEU433, TRP517, PHE907, TYR916 |
| 5 | Erythrosine | ASP424, GLU515, ASN537, ARG540 | THR426, GLY428, GLY429, ASP480, SER518, LEU541, SER589 | TRP517, TYR519 | |
| 6 | Erythromicin | THR426, TYR430 | ASP380, ASP424, GLY428, GLY429, LEU433, ASP480, ASN481, SER518, TYR519, ASN537, ASP588, TYR610, LYS977 | LEU382, TRP517 | |
Table 6: Amino acids on Ag I/II in volve in hydrogen and hydrophobic interaction with native ligand, betanin, isobetanin and neobetanin
| S. No. | Ligand | Amino acid residues | |||
| Hydrogen interaction | Hydrophobic interaction | Salt bridge/Attractive charge/Pi-cation | Pi-Pi stacked/Alkyl | ||
| 1 | Native ligand | THR652, SER818, ASN820, ARG824 | LEU653, SER697, ASP760, SER761, SER762, LYS822 | TRP816 | TRP816 |
| 2 | Betanin (1) | SER588, ASN589, GLU701, SER704, GLU706, ASP760, SER762, ASN814, ILE815 | ASP554, VAL587, PHE656, SER697, ASN699, ILE705, SER761, ALA787, LYS811, ARG824 | TRP816 | |
| 3 | Isobetanin (2) | ASN699, SER704, GLU706, SER762, LYS811, ASN814, TRP816, ARG824, | ASP554, THR586, VAL587, SER588, PHE656, SER697, ALA696, GLU701, TRP759, SER761, SER767, LYS812 | ASP760 | ASP760, ALA787, ILE815, TRP816 |
| 4 | Neobetanin (3) | ASN589, GLU701, SER704, GLU706, SER762, LYS811, LYS812, ASN814, TRP816, ARG824 | ASP554, VAL587, SER588, ASN590, PHE656, SER697, ASN699, ILE705, SER761, ASP763, ALA787, ILE815 | TRP816 | |
| 5 | Erythrosine | SER697 | ASP554, PHE656, ASN699, SER704, GLU706, ASP760, ASN814, TRP816 | GLU701 | PHE738, MET749, ALA787, ILE815 |
| 6 | Erythromicin | GLU706, PHE738, ASP760 | GLN552, ASP554, VAL664, SER697, ASN699, GLU701, ASN703, SER704, MET749, ALA787, GLY810, LYS811, LYS812 | ILE815, TRP816 | |
Antibacterial activity of beetroot extract
The antibacterial test aims to determine the activity of beetroot extract in inhibiting the growth of S. mutans, which is the main cause of dental caries. Beetroot extracts from three different areas, betanin, and Amoxicillin showed antibacterial activity by forming a clear zone (fig. 9). Beetroot extract from Magelang had a higher inhibition zone diameter than betanin and extracts from other areas (table 7). However, the measured inhibition zone diameter of the beetroot extract from Magelang was low compared to the inhibition zone diameter of Amoxicillin. The administration of beetroot extract from Magelang at a concentration of 1000 mg/ml only produced an inhibition zone of 12±3 mm, while the administration of Amoxicillin at a concentration of 0.5 mg/ml showed a much larger inhibition zone of 31.7 mm. Davis and Stout (1971) revealed that the diameter of the inhibition zone can be grouped into four categories, namely weak (<5 mm), moderate (5-10 mm), strong (10-20 mm), and very strong (>20 mm) [43]. However, the results of the inhibition zone measurements on the samples used in the research must be compared with positive controls that have been commercially used and proven to inhibit bacterial growth. Other results showed that the broth microdilution method of beetroot extracts from Magelang, West Bandung, Ciwidey, and betalain hadantibacterial activity against S. mutans with MIC values of 125 mg/ml and 250 mg/ml respectively (table 7). The MIC value shows that beetroot extract from Magelang has better antibacterial activity compared to beetroot extract from other areas previous studies have shown that beetroot ethanol extract can inhibit the growth of S. mutans, and the inhibitory activity increases with increasing concentration of the extract [44]. Other studies have shown that beetroot ethanol extract can inhibit g-positive bacteria, depending on the concentration [45]. Betalains from beetroot ethanol extract are known to inhibit the growth of E. fecalis, the antibacterial activity increases with increasing concentration [46]. However, in this study, the antibacterial activity of betanin inhibiting the growth of S. mutans was lower compared to the ethanol extract of beetroot from Magelang. This is possible because the ethanol extract of beetroot from Magelang not only contains betalain, but also contains other compounds that work synergistically to inhibit the growth of S. mutans. Previous studies have shown that beetroot antibacterial activity is possible due to the content of various other active compounds, such as phenols, flavonoids, saponins, and tannins [47, 48]. These active compounds cause various damages to the bacterial structure, thereby inhibiting the metabolism of the bacterial body and ultimately causing bacterial death [49–52]. Beetroot activity in inhibiting S. mutans needs to be studied further to validate its effectiveness as an agent that can inhibit the formation of dental caries. Further research also needs to determine the activity of beetroot in inhibiting other bacteria that cause dental caries, besides S. mutans.
Table 7: Antibacterial activity of beetroot extract against S. mutans
| Sample | Diameter of inhibition zone (mm) | MIC (mg/ml) | |
| Beetroot extract | Bandung Barat | 6.7±0.6 | 250.0±0.0 |
| Ciwidey | 6.7±0.6 | 250.0±0.0 | |
| Magelang | 12±3 | 125.0±0.0 | |
| Betanin | 6.0± 0.0 | 250±0.0 | |
| Amoxicillin (positive control) | 31.7±2.1 | 976.5x 10-6± 0.0 |
Value showed the mean±SD (n = 3)
Fig. 9: The diameter of inhibition zone from beetroot extract against S. mutans. A: Amoxicillin (positive control); BB: beetroot extract from Bandung Barat; C: beetroot extract from Ciwidey; M: beetroot extract from Magelang; Be: Betalain
CONCLUSION
Betalains from Beta vulgaris emerge as promising dual-function agents in oral healthcare, uniquely combining vibrant plaque detection with potent biofilm inhibition. Isobetanin, betanin and neobetanin exhibited excellent binding affinities toward glucosyltransferase and Ag I/II, two essential proteins in the biofilm formation of Streptococcus mutans, which was confirmed by highly accurate docking results with RMSD values below 4 Å. High solubility, low toxicity, and minimal systemic effects further reinforce their appropriateness for dental disclosing solutions. These findings underpin the potential transformative power of betalains as non-toxic, natural alternatives to synthetic dyes in dental applications, with comprehensive impacts on the development of new, efficient methods and means in diagnostics and prevention of oral health disorders. Further experimental validation will definitely fix their place as one of the cornerstones in next-generation dental formulations. In vitro studies have shown that beetroot ethanol extract can inhibit the growth of S. mutans better than betalain. This occurs because beetroot ethanol extract contains not only betalains but also other compounds that synergistically and comprehensively inhibit the growth of S. mutans. Further research is needed to investigate the effect of beetroot ethanol extract on inhibiting S. mutans biofilm formation, to understand the potential of beetroot as an active ingredient in disclosing solutions. Moreover, future direction will be focused on formulation of disclosing solution. The resulting disclosing solution will be tested in a laboratory to ensure its ability to effectively identify dental plaque on stored biological material in the form of extracted human tooth samples.
ACKNOWLEDGMENT
This work was supported by Rumah Program Organisasi Riset Kesehatan BRIN 2024. The authors also acknowledge the facilities, scientific and technical support from Botanical Characterization Laboratories, National Research and Innovation Agency through ELayanan Sains, Badan Riset dan Inovasi Nasional.
FUNDING
Rumah Program Organisasi Riset Kesehatan BRIN 2024.
AUTHORS CONTRIBUTIONS
Sofa Fajriah and Yahdiana Harahap contributed resources, conceptualization and supervision, and reviewing and editing of the manuscript; Nur Fitriana and Ilma Fauziah Ma'ruf to in silico study analysis; Rifaldi and Fadhila Utari to data curation, validation, and writing original manuscript, Susi Kusumaningrum contributed to UPLC analysis, Bantari Wisynu Kusuma Wardhani contributed to the writing original manuscript editing of the manuscript. Sri Ratna Laksmiastuti contributed to resources, while Reynatha C. A. Pangsibidang contributed to manuscript review and editing.
CONFLICTS OF INTERESTS
The authors declare no conflict of interest in this manuscript.
REFERENCES
Zhang G, Lu M, Liu R, Tian Y, Vu VH, Li Y. Inhibition of Streptococcus mutans biofilm formation and virulence by Lactobacillus plantarum K41 isolated from traditional Sichuan pickles. Front Microbiol. 2020 Apr;11:774. doi: 10.3389/fmicb.2020.00774, PMID 32425911.
Sun S, Lou Y, Weng X, Xie C, Ma H, Sun Z. Dent Al caries prevalence and caries-associated risk factors of students aged 12-15 in Xide County of Liangshan Prefecture China: a cross-sectional study. BMJ Open. 2024 Aug;14(8):e082922. doi: 10.1136/bmjopen-2023-082922, PMID 39645275.
Fasoulas A, Pavlidou E, Petridis D, Mantzorou M, Seroglou K, Giaginis C. Detection of dental plaque with disclosing agents in the context of preventive oral hygiene training programs. Heliyon. 2019 Jul;5(7):e02064. doi: 10.1016/j.heliyon.2019.e02064, PMID 31334380.
Furquim Dos Santos Cardoso V, Amaral Roppa RH, Antunes C, Silva Moraes AN, Santi L, Konrath EL. Efficacy of medicinal plant extracts as dental and periodontal antibiofilm agents: a systematic review of randomized clinical trials. J Ethnopharmacol. 2021 Aug;281:114541. doi: 10.1016/j.jep.2021.114541, PMID 34416298.
Budala DG, Martu MA, Maftei GA, Diaconu Popa DA, Danila V, Luchian I. The role of natural compounds in optimizing contemporary dental treatment-current status and future trends. J Funct Biomater. 2023;14(5):273. doi: 10.3390/jfb14050273, PMID 37233383.
Montoya C, Roldan L, Yu M, Valliani S, Ta C, Yang M. Smart dental materials for antimicrobial applications. Bioact Mater. 2023 Dec;24:1-19. doi: 10.1016/j.bioactmat.2022.12.002, PMID 36582351.
Fu Y, Shi J, Xie SY, Zhang TY, Soladoye OP, Aluko RE. Red beetroot betalains: perspectives on extraction processing and potential health benefits. J Agric Food Chem. 2020 Oct;68(42):11595-611. doi: 10.1021/acs.jafc.0c04241, PMID 33040529.
S Gabal AM, M Morsy G. Impact of beetroot (Beta vulgaris RUBRA) and/or Swiss chard (Beta vulgaris CICLA) juices oral administration against barium chloride-induced hypokalemia atpase disturbance and heart and lung toxicity in rats. Asian J Pharm Clin Res. 2020;13(8):218-24. doi: 10.22159/ajpcr.2020.v13i8.38232.
Wijesinghe VN, Choo WS. Antimicrobial betalains. J Appl Microbiol. 2022 Sep;133(6):3347-67. doi: 10.1111/jam.15798, PMID 36036373.
Kusznierewicz B, Mroz M, Koss Mikolajczyk I, Namiesnik J. Comparative evaluation of different methods for determining phytochemicals and antioxidant activity in products containing betalains verification of beetroot samples. Food Chem. 2021 Nov;362:130132. doi: 10.1016/j.foodchem.2021.130132, PMID 34082297.
Sadowska Bartosz I, Bartosz G. Biological properties and applications of betalains. Molecules. 2021 Apr;26(9):2520. doi: 10.3390/molecules26092520, PMID 33925891.
Martinez Rodriguez P, Guerrero Rubio MA, Henarejos Escudero P, Garcia Carmona F, Gandia Herrero F. Health promoting potential of betalains in vivo and their relevance as functional ingredients: a review. Trends Food Sci Technol. 2022 Apr;122:66-82. doi: 10.1016/j.tifs.2022.02.020.
Jauhar MM, Syaifie PH, Arda AG, Ramadhan D, Nugroho DW, Ningsih Kaswati NM. Evaluation of propolis activity as sucrose-dependent and sucrose-independent Streptococcus mutans inhibitors to treat dental caries using an in silico approach. J App Pharm Sci. 2022;13(3):71-80. doi: 10.7324/JAPS.2023.45365.
Rivera Quiroga RE, Cardona N, Padilla L, Rivera W, Rocha Roa C, Diaz De Rienzo MA. In silico selection and in vitro evaluation of new molecules that inhibit the adhesion of Streptococcus mutants through antigen I/II. Int J Mol Sci. 2020 Dec;22(1):377. doi: 10.3390/ijms22010377, PMID 33396525.
Bess A, Berglind F, Mukhopadhyay S, Brylinski M, Griggs N, Cho T. Artificial intelligence for the discovery of novel antimicrobial agents for emerging infectious diseases. Drug Discov Today. 2022 Nov;27(4):1099-107. doi: 10.1016/j.drudis.2021.10.022, PMID 34748992.
Asiamah I, Obiri SA, Tamekloe W, Armah FA, Borquaye LS. Applications of molecular docking in natural products-based drug discovery. Sci Afr. 2023 Jul;20:e01593. doi: 10.1016/j.sciaf.2023.e01593.
Singh A. Artificial intelligence for drug repurposing against infectious diseases. Artif Intell Chem. 2024;2(2):100071. doi: 10.1016/j.aichem.2024.100071.
Singh A, Jatav VK, Sharma S. Virtual screening and admet analysis for identification of inhibitors against acetylcholinesterase associated with Alzheimer’s disease. Int J Pharm Pharm Sci. 2014 Oct;6(10):155-9.
Rotich V, Wangila P, Cherutoi J. Method validation and characterization of red pigment in Beta vulgaris peels and pomaces by HPLC-UV and UHPLC-MS/MS. J Anal Methods Chem. 2022 Aug;2022:2229500. doi: 10.1155/2022/2229500, PMID 36052342.
Wybraniec S, Starzak K, Szneler E, Pietrzkowski Z. Separation of chlorinated diastereomers of decarboxy-betacyanins in myeloperoxidase-catalyzed chlorinated Beta vulgaris L. extract. J Chromatogr B Analyt Technol Biomed Life Sci. 2016 Nov;1036-1037:20-32. doi: 10.1016/j.jchromb.2016.09.040, PMID 27710887.
Hempel J, Bohm H. Betaxanthin pattern of hairy roots from Beta vulgaris var. lutea and its alteration by feeding of amino acids. Phytochemistry. 1997 Mar;44(5):847-52. doi: 10.1016/S0031-9422(96)00633-4.
Hanwell MD, Curtis DE, Lonie DC, Vandermeersch T, Zurek E, Hutchison GR. Avogadro: an advanced semantic chemical editor visualization and analysis platform. J Cheminform. 2012 Aug;4(1):17. doi: 10.1186/1758-2946-4-17, PMID 22889332.
Dallakyan S, Olson AJ. Small-molecule library screening by docking with PyRx. Methods Mol Biol. 2015;1263:243-50. doi: 10.1007/978-1-4939-2269-7_19, PMID 25618350.
Eberhardt J, Santos Martins D, Tillack AF, Forli S. Autodock vina 1.2.0: New docking methods expanded force field and python bindings. J Chem Inf Model. 2021 Jul;61(8):3891-8. doi: 10.1021/acs.jcim.1c00203, PMID 34278794.
Bell EW, Zhang Y. Dock RMSD: an open-source tool for atom mapping and RMSD calculation of symmetric molecules through graph isomorphism. J Cheminform. 2019 Jun;11(1):40. doi: 10.1186/s13321-019-0362-7, PMID 31175455.
Che X, Liu Q, Zhang L. An accurate and universal protein-small molecule batch docking solution using autodock vina. Results Eng. 2023 Sep;19:101335. doi: 10.1016/j.rineng.2023.101335.
Che X, Zhang L. Blind docking methods have been inappropriately used in most network pharmacology analysis. Front Pharmacol. 2025 Mar;16:1566772. doi: 10.3389/fphar.2025.1566772, PMID 40196361.
Pettersen EF, Goddard TD, Huang CC, Couch GS, Greenblatt DM, Meng EC. UCSF Chimera a visualization system for exploratory research and analysis. J Comput Chem. 2004 Oct;25(13):1605-12. doi: 10.1002/jcc.20084, PMID 15264254.
Septama AW, Tasfiyati AN, Kristiana R, Jaisi A. Chemical profiles of essential oil from Javanese turmeric (Curcuma Xanthorrhiza Roxb.) evaluation of its antibacterial and antibiofilm activities against selected clinical isolates. S Afr J Bot. 2022;146:728-34. doi: 10.1016/j.sajb.2021.12.017.
Ojo OA, Gyebi GA, Ezenabor EH, Iyobhebhe M, Emmanuel DA, Adelowo OA. Exploring beetroot (Beta vulgaris L.) for diabetes mellitus and Alzheimer’s disease dual therapy: in vitro and computational studies. RSC Adv. 2024 Jun;14(27):19362-80. doi: 10.1039/d4ra03638g, PMID 38887650.
Daina A, Michielin O, Zoete V. Swiss ADME: a free web tool to evaluate pharmacokinetics drug likeness and medicinal chemistry friendliness of small molecules. Sci Rep. 2017 Mar;7:42717. doi: 10.1038/srep42717, PMID 28256516.
Di Stefano M, Galati S, Piazza L, Granchi C, Mancini S, Fratini F. VenomPred 2.0: a novel in silico platform for an extended and human interpretable toxicological profiling of small molecules. J Chem Inf Model. 2024 Jul;64(7):2275-89. doi: 10.1021/acs.jcim.3c00692, PMID 37676238.
Mobitz H. Design principles for balancing lipophilicity and permeability in beyond rule of 5 space. ChemMedChem. 2024;19(5):e202300395. doi: 10.1002/cmdc.202300395, PMID 37986275.
Rancan F, Volkmann H, Giulbudagian M, Schumacher F, Stanko JI, Kleuser B. Dermal delivery of the high-molecular-weight drug tacrolimus by means of polyglycerol-based nanogels. Pharmaceutics. 2019 Aug;11(8):394. doi: 10.3390/pharmaceutics11080394, PMID 31387279.
Liu S, Deng T, Cheng H, Lu J, Wu J. Advances in transdermal drug delivery systems and clinical applications in inflammatory skin diseases. Pharmaceutics. 2025 Jun;17(6):746. doi: 10.3390/pharmaceutics17060746, PMID 40574058.
Bonet IJ, Araldi D, Green PG, Levine JD. Topical coapplication of hyaluronan with transdermal drug delivery enhancers attenuates inflammatory and neuropathic pain. Pain. 2023 Jul;164(12):2653-64. doi: 10.1097/j.pain.0000000000002993, PMID 37467181.
Knoll KE, Van Der Walt MM, Loots DT. In silico drug discovery strategies identified ADMET properties of decoquinate RMB041 and its potential drug targets against Mycobacterium tuberculosis. Microbiol Spectr. 2022 Mar;10(2):e0231521. doi: 10.1128/spectrum.02315-21, PMID 35352998.
Suwendar S, Sani Ega P, Dina M, Taufik Muhammad F, Ibrahim J. Assessment of phytochemicals from Syzygium aqueum as inhibitors of ATP-dependent 6-phosphofructokinase: in silico and in vitro studies. Pharmacia. 2024;71:1-17. doi: 10.3897/pharmacia.71.
Hamdoon YS, Hadi MK. Molecular docking ADMET synthesis and evaluation of new indomethacin hydrazide derivatives as antibacterial agents. Pharmacia. 2024;71:1-10. doi: 10.3897/pharmacia.71.e127784.
Dhapte Pawar V, Kothe B, Bhadekar R. Exploring potential of tobramycin complexes for combating biofilms: in silico and in vitro studies. Hybrid Adv. 2024;7:100328. doi: 10.1016/j.hybadv.2024.100328.
Martins FG, Melo A, Sousa SF. Identification of new potential inhibitors of quorum sensing through a specialized multi-level computational approach. Molecules. 2021 Apr;26(9):2600. doi: 10.3390/molecules26092600, PMID 33946907.
Gamboa F, Gomez OL, Alvarado A, Bustillo J. Antimicrobial susceptibility of Streptococcus mutans biotypes. Int J Infect Dis. 2008;12:e257. doi: 10.1016/j.ijid.2008.05.695.
Davis WW, Stout TR. Disc plate method of microbiological antibiotic assay. I. factors influencing variability and error. Appl Microbiol. 1971 Oct;22(4):659-65. doi: 10.1128/am.22.4.659-665.1971, PMID 5002143.
Ulfa Y, Adjiedarmo I, Christianti Y, Sulistiawati S, Negara M. Antibacterial effectiveness of beetroot against Streptococcus mutans. B-Dent J Kedokteran Gigi Univ Baiturrahmah. 2022 Jun;9(1):33-43. doi: 10.33854/jbd.v9i1.938.
Saani M, Lawrence R. Beta vulgaris Root extracts: as free radical scavengers and antibacterial agent. Orient J Chem. 2020 Aug;36(4):733-41. doi: 10.13005/ojc/360419.
Vijaya D, Thangaraj N. Extraction of betalains from red beetroot (Beta vulgaris L.) and to evaluate its antibacterial potential against extended-spectrum beta-lactamase producing isolates. J Pharm Sci Res. 2019 Jun;11(6):2422-5.
El Beltagi H, Mohamed H, Megahed B, Gamal M, Safwat G. Evaluation of some chemical constituents antioxidant, antibacterial and anticancer activities of Beta vulgaris L. root. Fresenius Environ Bull. 2018 Aug;27(9):6369-78.
Omogbai BA, Omoregie IA. Chemical analysis and biological activity of natural preservative from beet root (Beta vulgaris) against foodborne pathogens and spoilage organisms. Afr Sci. 2016 Jun;17(2):135-45.
Setyorini D, Rahayu Y. The effect of rinsing Red beet root (Beta vulgaris L.) juice on Streptocoocus sp dental plaque. J Dentomaxillofac Sci. 2017 Apr;2(1):15-7. doi: 10.15562/jdmfs.v2i1.460.
Chen M, Zhao Z, Meng H, Yu S. The antibiotic activity and mechanisms of sugar beet (Beta vulgaris) molasses polyphenols against selected food-borne pathogens. LWT. 2017 Sep;82:354-60. doi: 10.1016/j.lwt.2017.04.063.
Cipriano Salazar M, Rojas Hernandez S, Olivares Perez J, Jimenez Guillen R, Cruz Lagunas B, Camacho Diaz LM. Antibacterial activities of tannic acid against isolated ruminal bacteria from sheep. Microb Pathog. 2018 Feb;117:255-8. doi: 10.1016/j.micpath.2018.01.045, PMID 29471138.
Herawati D, Ekawati ER, Yusmiati SN. Identification of saponins and flavonoids in lime (Citrus aurantifolia) peel extract. In: Proceedings of the 5th NA international conference on industrial engineering and operations management; 2020. p. 3661-6.








